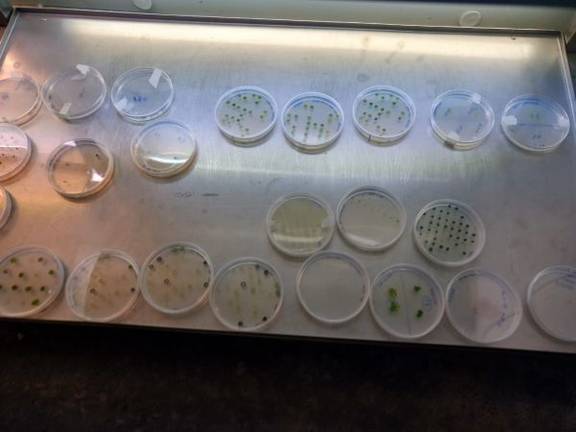

La clave para combatir el dolor crónico puede estar en Marismas del Odiel
La clave para combatir el dolor crónico puede estar en uno de los organismos más antiguos que existen, encontrado en Marismas del Odiel. Es una de las investigaciones que está realizando Algaret+, un proyecto de cooperación transfronterizo en el que participan universidades, empresas e instituciones de investigación de ambos lados de la frontera, del Algarve y de Huelva, Cádiz y Córdoba.
Liderada por la Universidad de Huelva, la investigación ha encontrado en las salinas de Marismas del Odiel microorganismos estremófilos. Con concentraciones de 300 gramos de sal por litro, ahí no vive casi nadie. La coordinadora del proyecto, la catedrática de bioquímica Rosa León, explica que han aislado una arquea, que es un microorganismo muy antiguo, más antiguo que la mayoría de las bacterias: "Hemos hecho un estudio y hemos visto que hay una gran biodiversidad de arqueas, hemos encontrado por lo menos 20 especies diferentes, algunas curiosísimas, son cuadradas, algo muy raro. Hemos mandado estratos de estas arqueas a una empresa colaboradora y han encontrado estratos muy interesantes contra el dolor crónico".
El hallazgo abre una vía de esperanza para los pacientes aquejados de dolor crónico. Rosa León advierte de que la investigación es muy incipiente. "Se trata de una investigación básica porque este proyecto Algaret+ tiene varias partes: la bioprospección y búsqueda de nuevas especies; otra busca las bioactividades de esas especies aisladas y estudia el metabolismo de las microalgas para poder manipularlo; y la última es buscar aplicaciones en acuicultura para complementar las dietas de los peces".

Solucionar un gran problema en acuicultura
La coordinadora de Algaret+ señala que en acuicultura hay un problema muy grande. Es el sector alimentario que más ha crecido en los últimos años, se ha igualado el pescado que se extrae por captura al que se extrae por acuicultura. En los estadios iniciales, estos pescados de la acuicultura necesitan ciertos nutrientes, como omega 3 u omega 6, que se obtienen de los aceites de pescado. "Es como un círculo: necesitas pescado para extraer aceite de pescado y alimentar al pescado", expone León.
Estos aceites y harinas de pescado se están encareciendo cada vez más y están empezando a escasear, por lo que se están investigando otras fuentes. "Hablas con expertos en acuicultura y te dicen: buscad urgente porque estamos sin recursos para alimentar a tanta acuicultura. Y las microalgas son la fuente natural de estos ácidos grasos poliinsaturados. Los aceites de pescado tienen PUFAs porque las han asimilado de las algas, porque los peces no pueden producirlas, igual que nos pasa con las vitaminas".
Pero ahora mismo, el cultivo de las microalgas, su recolección y procesamiento es más caro que obtenerlo en harinas de pescado. Entonces, el objetivo es también abaratar los sistemas de producción. Según la coordinadora de Algaret+, "podemos hacer que crezcan más vigorosamente o que tengan más proporción del compuesto que nos interesa. Lograríamos más productividad. Tenemos otra línea de trabajo que es la mejora genética de las microalgas para lograr que crezcan más deprisa o que tengan más compuestos de nuestro interés". Explica Rosa León que se han centrado en los carotenoides, que son pigmentos esenciales que tenemos que ingerir. Están en la retina en la mancha lútea, "se está viendo ahora que la única forma de prevenir la degeneración macular, la principal causa de ceguera en Europa, es mediante la ingesta de luteína y zeasantina. Estamos buscando microalgas mejoradas genéticamente que sean capaces de acumular mayores cantidades de estos compuestos, que están en todos los vegetales, hay que comer mucha fruta y verdura", porque "todos los átomos de carbono que tenemos han pasado antes por una planta", recalca la investigadora.
En Algaret+ ya tienen aisladas más de 60 nuevas especies y han sacado 9 publicaciones científicas de primer nivel con los distintos socios. "Nuestro objetivo es caracterizarlas nutricionalmente, tiene que estar listo antes de que acabe el proyecto", fijado a finales de 2019, pero para el que pedirán una prórroga ya que se empezó con retraso. "Luego tendremos a mitad del año que viene un meeting en Portugal y todos los socios comunicarán sus avances, sobre todo los que están buscando esos fármacos. Es verdad que las investigaciones en biotecnología a veces tienen tiempos largos, pero vamos a conseguir nuestro objetivo en estos fármacos contra el dolor crónico, ya hay dos o tres extractos que están dando sus frutos, hay que seguir investigándolos" apunta León.

El boom de las microalgas
La Universidad de Huelva lleva 20 años trabajando con microalgas, es pionera en la manipulación genética de las microalgas en Europa junto con el grupo de Emilio Fernández de Córdoba. Rosa León asegura que ahora ha habido un boom a raíz de utilizar microalgas para la obtención de biodiésel, que se obtiene de los lípidos de las plantas, pero estás quitando comida para hacer biocombustible. Algunas microalgas son capaces de producir cantidades importantes de aceites y podrían ser una alternativa. En este sentido, la investigadora de la Onubense explica que es caro todavía, las microalgas tienen mercado, como la producción de betacaroteno, pero suelen ser compuestos de alto valor añadido. "Te venden una cremita o unas pildoritas para el verano y pagas 30 euros por una cajita y sales tan feliz. Con el biodiésel hay que competir con el precio del petróleo y no es rentable. Las microalgas son caras de producir y se utilizan para compuestos de alto valor añadido: dietética, farmacéutica, cosmética... pero en productos base hay que competir en precio", apunta León, quien reconoce que este boom ha tenido el lado positivo de fomentar la investigación con microalgas, "sobre todo en la investigación genética, en la que estaba todo muy paradito, éramos 3 o 4 en España los que lo hacíamos".

Una vacuna para la lubina
La Universidad de Huelva tiene otro proyecto financiado por el Ministerio de Economía y Empresa en el que participan las Universidades de Almería y Murcia. "Todas las proteínas se producen a partir de un gen, si nosotros a una microalga le metemos un gen que no es suyo va a producir esa proteína, eso ya se hace por ejemplo con la insulina. Antiguamente la insulina se extraía del cerdo, había que coger el páncreas del cerdo y extraer insulina. Nosotros solo nos diferenciamos en un aminoácido con la insulina del cerdo. Ahora ya tenemos insulina humana que la fabrican bacterias para nosotros", señala Rosa León.
Este proyecto busca una vacuna para lubina. El nodavirus causa mortalidades muy grandes a la lubina, "nosotros tenemos unas de las proteínas de ese virus, podemos obligar a la microalga a que produzca esta proteína, que es un antígeno, cuando el pez lo ingiera, va a estar protegido". La originalidad de esto es que "queremos que sea una vacuna oral porque la vacuna parental es muy costosa en los peces, sobre todo sin son pequeños, que es cuando más mortalidad tienen. Estamos haciendo muchos esfuerzos en mejorar los niveles de expresión de proteínas en las microalgas. La parte nuestra, que es tener microalgas que expresen grandes cantidades de proteínas, tiene que estar a mitad del año que viene. Los colegas de Murcia son los que hacen los experimentos con los peces, y veremos si tiene éxito", concluye León, para quien supondría un gran avance porque este virus causa estragos en la lubina y al sector le perjudica mucho: "Nos abriría las puertas a otras vacunas".